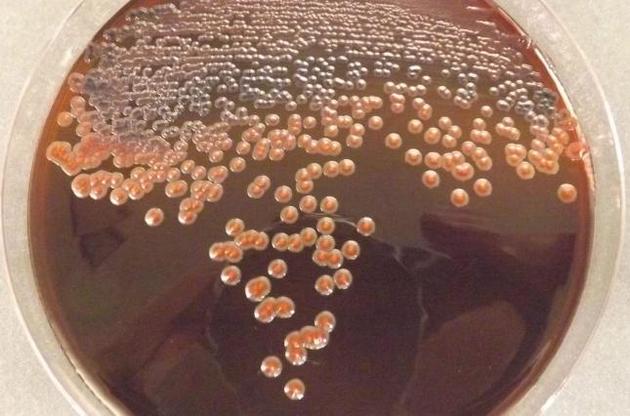
Бактерии могут помочь справиться с токсичными отходами

Группа ученых из Германии обнаружила бактерии, которые способны перерабатывать токсичные соединения, используя их в качестве источников углерода, азота и энергии. Как сообщает Naked science, в процессе микроорганизмы расщепляют некоторые строительные блоки на основе полиуретана.
Ученые утверждают, что их открытие – важный шаг на пути к возможности повторного использования изделий из полиуретана. Ежегодно только в Европе создают миллионы тонн изделий из этого материала. Основная часть таких соединений – термореактивные полимеры, которые не плавятся при нагревании. После попадания на свалки или в дикую природу, полиуретановые отходы начинают выделять токсичные вещества. Чтобы сделать такие материалы биоразлагаемыми, нужна промежуточная переработка бактериями, которые и ищут в рамках специальной программы ЕС.
Выделенный учеными штамм относится к группе бактерий, которые известны своей устойчивостью к токсичным органическим соединениям. Следующим шагом по изучению находки, по словам исследователей, будет идентификация генов, которые кодируют у этой бактерии внеклеточные ферменты. Такие энзимы способны расщеплять определенные химические соединения в полиуретанах на основе сложных полиэфиров. Эти вещества, они же экзоферменты, по сути своей белки, выделяемые вне клетки и вызывающие биохимическую реакцию.
Подписывайтесь на наш Telegram-канал с новостями технологий и культуры.
Ранее ученые из фонда Ocean Cleanup Foundation провели новую оценку Большого тихоокеанского мусорного пятна и заявили о том, что его размеры в три раза превышают территорию Франции.